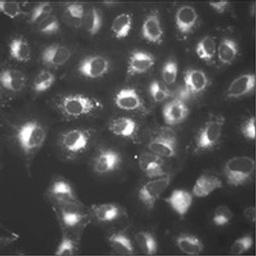

DRAQ9
Far-red fluorescent cell permeant nuclear "dark" probe for cell tracking and cell painting

The supplier does not provide quotations for this product through SelectScience. You can search for similar products in our Product Directory.
Good lipid stain
Short-term membrane staining
DRAQ9 was a gift from BioStatus. We used it to determine if the vacuoles that we were observing in mammalian cells under hypotonic stress are surrounded by a lipid membrane. DiI that we tried before failed to stain the vacuoles, but with DRAQ9 the result was unequivocally positive: a bright staining was easily detectable under a confocal microscope. The presence of lipid was confirmed with Nile Red. We published the image in Fig. 5 of https://www.nature.com/articles/s41598-024-79815-z.pdf
Review Date: 2 Jan 2025 | Biostatus Limited
DRAQ9™ is a new member of the DRAQ™ family of probes, specficially designed for the following applications:
- Long-term cell tracking: DRAQ9 is non-toxic and nuclear "dark"
- Cell painting / cell mosaic: DRAQ9 labels membranous structures (e.g. Golgi body) in live- or fixed-end point assays to reveal phenotypic changes